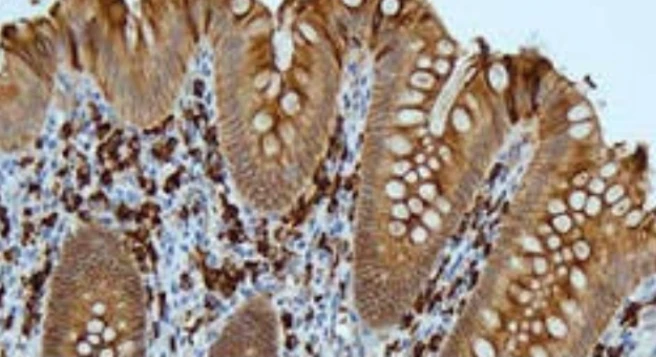
Immunohistochemistry: IgA

تفاصيل التحليل
فحص ترسبات الأجسام المضادة IgA نسيجياً (IgA)
تحليل دقيق لتشخيص أمراض الكلى والجلد المناعية عبر رصد ترسبات IgA في الأنسجة، مما يساعد في تحديد بروتوكول العلاج المناعي المناسب لحالتك.
الصورة التوضيحية المرتبطة بهذا التحليل